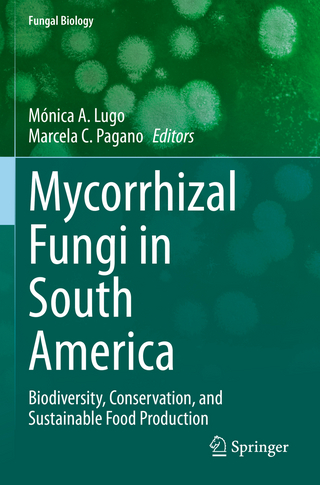
Mycorrhizal Fungi in South America

A Natural History of Our Planet's Decomposers
Buch | Hardcover
2022
|
Princeton University Press
ISBN: 9780691229843
CHF 43,60 (inkl. MwSt)
- Versand in
10-20 Tagen